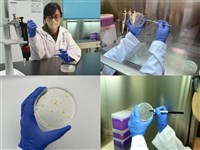
紐西蘭乳品將零關稅  畜試所籲用快檢術精進品管

# 黃振芳
最新27篇文章
更新時間:2025/12/08 21:53:33 生活
生活蛋雞場升級衛生環境 跑跳空間助產蛋率增逾1成
2025/07/03 13:42 生活
生活源興牛、平埔黑豬育成 搶進海內外中高階市場
2024/11/08 14:49![紐西蘭鹿茸將零關稅 國產轉型質精還開發化粧品]() 生活
生活紐西蘭鹿茸將零關稅 國產轉型質精還開發化粧品
2024/09/06 14:24![全台首座「三綠溫室」啟用 打造永續牧草產業]() 生活
生活全台首座「三綠溫室」啟用 打造永續牧草產業
2024/04/04 18:32![紐西蘭乳品將零關稅 畜試所籲用快檢術精進品管]() 生活
生活紐西蘭乳品將零關稅 畜試所籲用快檢術精進品管
2024/01/17 13:14![4隻草鴞寶寶現蹤台南草叢 緊急搭建圍網保護]() 生活
生活4隻草鴞寶寶現蹤台南草叢 緊急搭建圍網保護
2023/11/11 12:57- 生活
畜試所輔導友善飼養 19部落推特色雞肉雞蛋
2023/08/23 18:42 - 生活
滿足學做莫札瑞拉起司的心 畜試所專研製程傳授
2023/02/09 11:02 - 生活
因疫情停辦2年 台南農畜聯合開放日12/4登場
2022/11/30 13:03 - 生活
氣象局與畜試所合作 加強畜牧業氣候變遷調適
2022/11/30 13:03 - 生活
種鴨驗出H5N1禽流感成全台首例 畜試所疑病毒變異
2022/11/23 11:12 - 生活
畜試所母豬AI生育技術 省人力並創上億元產值
2022/11/09 19:20 - 生活
迎戰紐西蘭進口鹿茸 國產鹿茸推標章品質掛保證
2022/07/01 18:34 - 生活
桃園豬冷凍精液技術無虞 產胎數與自然配種一致
2022/01/25 11:28 - 地方
農委會與金門畜試所簽備忘錄 提升在地產業發展
2021/12/20 17:50 - 產經
台糖攜手農委會畜試所 拚永續畜產國際競爭力
2021/08/16 14:44 - 生活
循環農業推動有成 減廢減碳催生8億元投資
2020/11/03 19:47 - 生活
芒果仁豬內臟再利用 減少糧食浪費加值技術發表
2020/10/16 17:33 - 生活
太空包變蒸氣年賺2億元 循環農業展示商機
2020/10/06 14:09 - 產經
3D自動量測種豬體型機問世 助養豬產業升級
2020/09/09 14:45 - 生活
最佳豬隊友 屏東餐飲品牌18家店齊挺台豬
2020/09/03 22:18 - 生活
家禽脂肪翻身變清澈 雞油角可做清真香腸
2020/07/08 20:58 - 生活
鹹蛋黃萃製金沙粉蛋黃油 畜試所研發無添加技術
2019/11/12 17:55 - 地方
國際海牛文化節6日開幕 體驗牛車採蚵
2019/10/06 14:28 - 生活
防非洲豬瘟鼓勵改餵飼料 換肉率良否有歧見
2018/12/24 20:30 - 產經
小肉豬死亡率增加 專家籲改善養豬環境
2017/08/08 12:15 - 產經
薑母鴨店圖 正名五結黑色番鴨
2014/06/18 19:47
新聞小百科
#

請輸入正確的電子信箱格式
請輸入正確的電子信箱格式 



